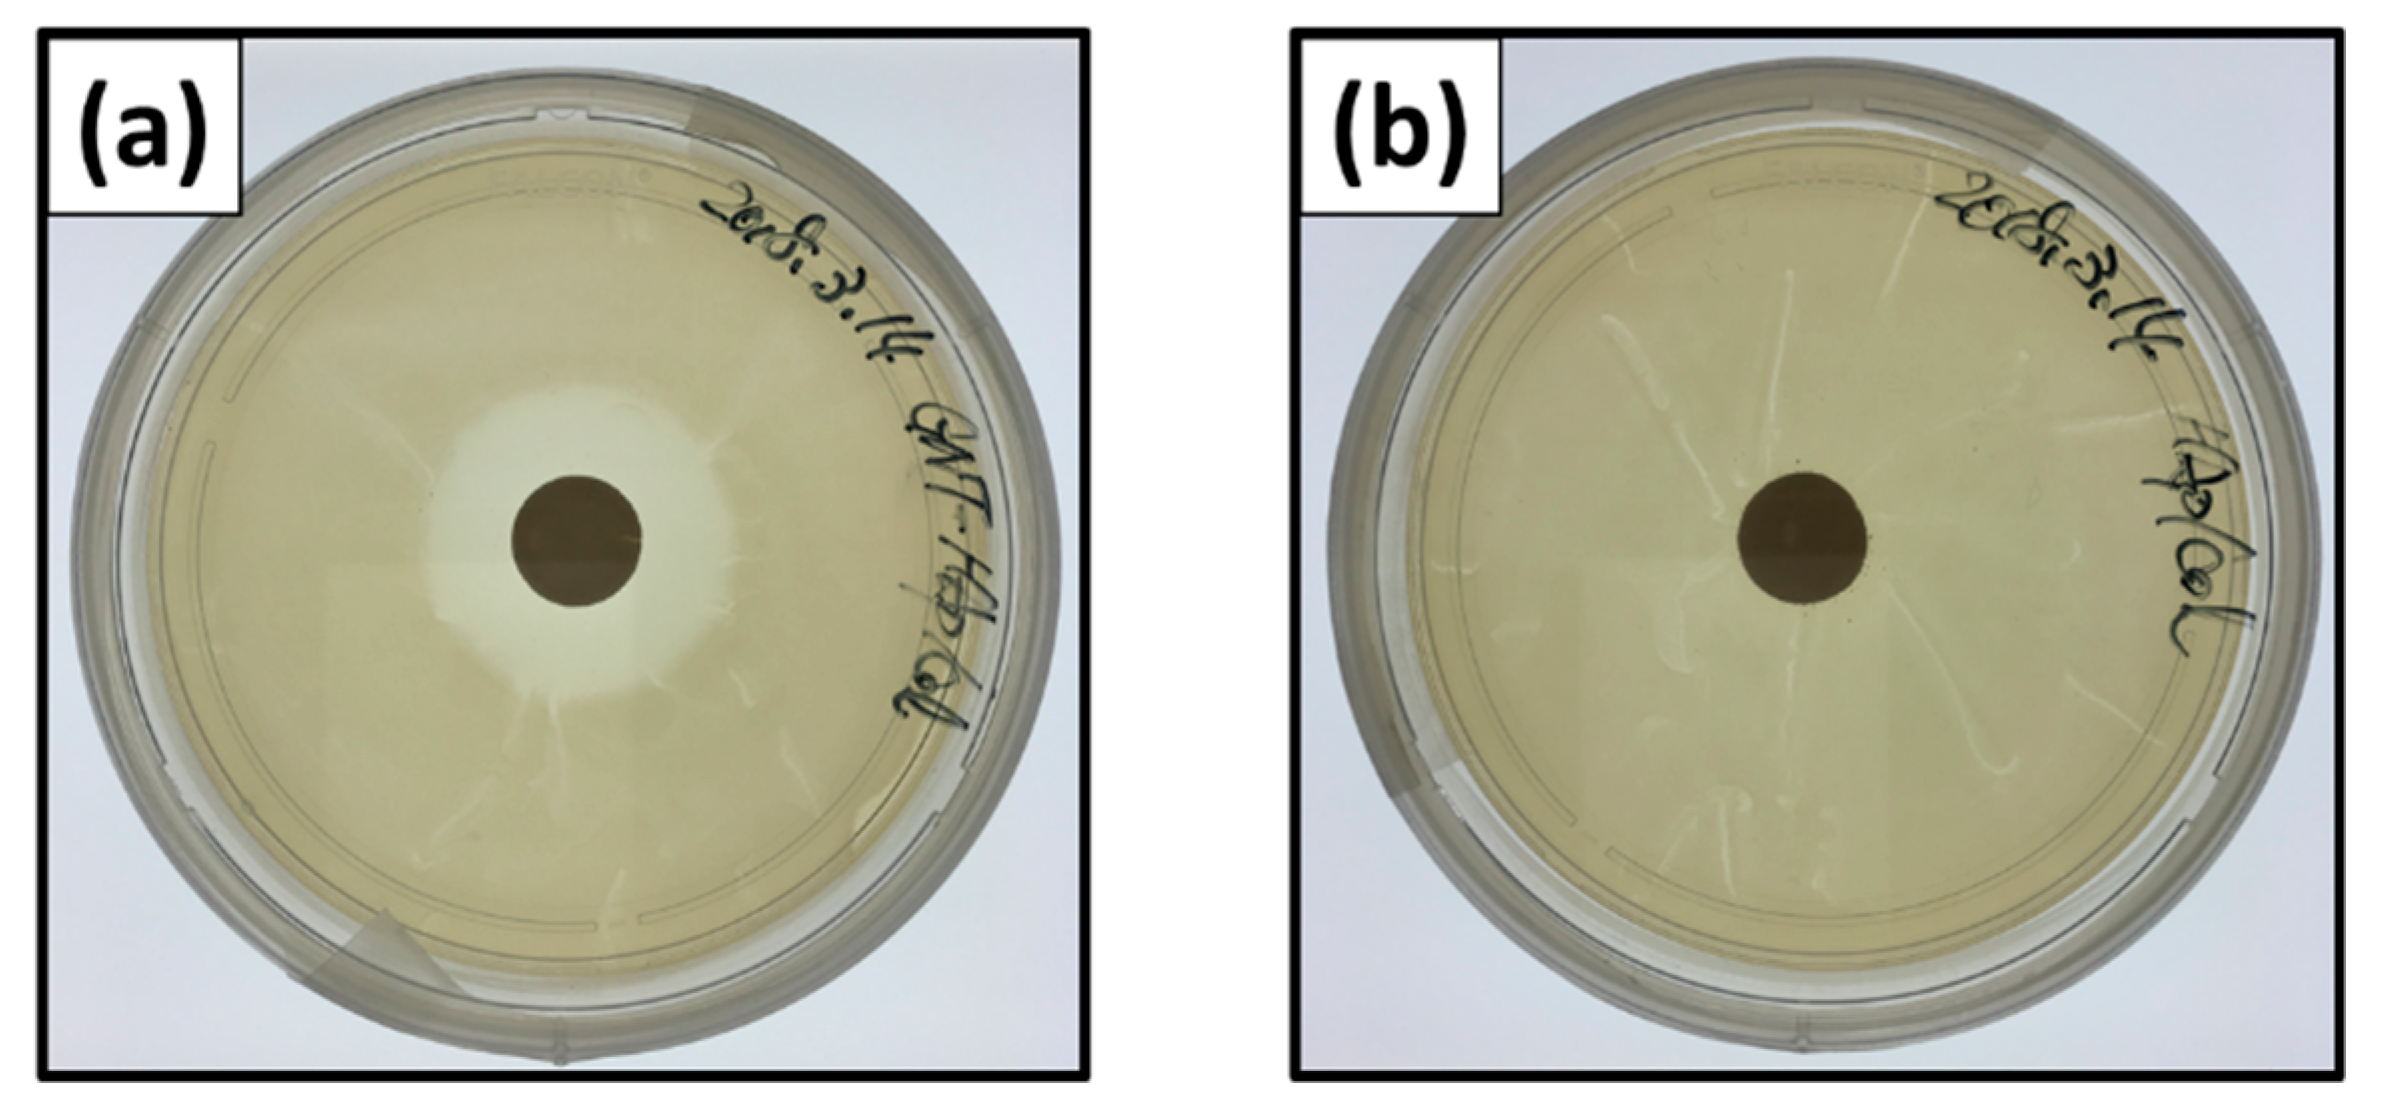
Ijms 21 00551 g005

1. Introduction
Mainstream ceramic bone void fillers are osteoconductive in nature, and research trends are moving towards the improvement of other biological activities, osteogenic activity, and biodegradability including bioresorbability and antibacterial activity by controlling chemical composition and embedding of biofunctional molecules, including drugs. The addition of antibacterial activity is one of the important issues with regards to the fillers in terms of preventing infection after their implantation (implant-associated infection, IAI) that are increasing in developing countries and cause severe disease. The greatest cause of IAIs is biofilm formation on the surface of implants [
1] and resisting immune reaction [
2]. The general method to prevent infections including IAI is intravenous injection of antibiotics [
3]; however, thorough dose control is necessary to reduce side-effects and appearance of drug-resistant bacteria. Thus, local delivery of antibiotics from the fillers has been studied to overcome the aforementioned risks. At least two antibacterial biomaterials for artificial joint surgery are on the market and are practically used. One is a gentamicin sulfate (GNT) impregnated polymethylmethacrylate (PMMA) bone cement, Palacos
® bone cement (Zimmer Inc., USA), developed according to the report of Wahlig and Buchholz [
4] in 1972, and its gradual and local release of GNT reduces risks of occurrence of drug-resistant bacteria [
5] and medical costs. The other is a hip-joint coated with hydroxyapatite (HAp, Ca
5(PO
4)
3OH) and Ag, Ag-PROTEX
® ( KYOCERA Corporation, Japan), and gradual release of Ag ions inhibiting bacteria proliferation for up to 7 days. However, no bone void fillers equipped with antibacterial properties have been commercialized, despite their study by some researchers [
5,
6].
We focused on biodegradability as an important factor for antibacterial bone void fillers, as it reduces the risk of biofilm formation on the surface of the fillers, possible scaffolds for bacteria. Therefore, HAp ceramic-based bone void fillers are not suitable. In addition, ceramic HAp and β-tricalcium phosphate (TCP, Ca3(PO4)2) have lower specific surface area compared with wet-prepared materials; thus, they are not suitable for embedding sufficient amounts of antibacterial drugs.
In contrast, nanocomposites of HAp and collagen are already used practically. One is the HEALOS
® (DePuy Spine Inc., USA), and the other is the ReFit
® (HOYA Technosurgical Co., Japan). HEALOS
® is collagen-coated with thick HAp formed using a biomimetic method, such as simulated body fluid soaking; therefore, HEALOS
® has no similarity to the nanostructure of bone. ReFit
®, developed and reported by us as a “hydroxyapatite/collagen bone-like nanocomposite (HAp/Col)”, is a self-organized nanocomposite of HAp and collagen (Col) having bone-like chemical composition and oriented nanostructure of HAp nanocrystals and Col fibers. According to the structure, HAp/Col would have a higher specific surface area than conventional ceramics and may have numerous adsorption sites for antibiotics/drugs on both HAp and Col. In addition, the HAp/Col [
7] is substituted with newly formed bone within 3–6 months by incorporation into the bone remodeling process, which is faster than other biodegradable ceramic bone void fillers [
8]. These properties are suitable for antibacterial bone void fillers for prophylaxis of IAIs. As an antibiotic, the GNT was chosen for a model antibiotic and candidate drug, because it is widely applied as an antibiotic to prevent general infections, including IAI, and has many advantages, such as low cost, broad antibacterial spectrum of action, low rate of primarily resistant pathogens, and good stability in terms of long shelf-life [
9,
10]. Furthermore, GNT is effective against most Gram-negative microorganisms and has a low risk of inducing resistant bacteria, as well as being able to be used for treatment of IAI by introduction into Palacos
®.
In this study, the potential of HAp/Col powder as an antibacterial bone void filler was evaluated by measuring adsorption and desorption properties of GNT on HAp/Col powder, and the antibacterial properties and cytotoxicity of GNT-loaded HAp/Col (GNT-HAp/Col) powder.
3. Discussions
When the HAp/Col powder was assumed to be a dense sphere of 156 μm of mean powder diameter, the theoretical value of the specific surface area was 0.02 m
2/g (1), where
r is the radius of the particle. As compared with this theoretical value, the specific surface area of the original HAp/Col powder was much bigger because micro- and/or nanopores in the HAp/Col powder were formed during the freeze-drying process.
After the GNT-loading process, the particle size of the HAp/Col powder decreased from 100–212 µm (
Figure 1a) to 30–40 µm (
Figure 1b) in diameter. Obviously, the diameter decrease led to an increase in surface area; however, the above results were opposite to the size effect. Here, theoretical particle size effect for solid sphere of the HAp/Col (its density at HAp/Col mass ratio of 4:1 was approximately 2.38 g/cm
3) was related to the reciprocal value of diameter, as shown in Equation (1). Thus, the decrease in solid HAp/Col particle diameter from 200 µm to 20 µm only increased the specific surface area from 0.013 to 0.13 m
2/g, and was less than 0.5% against the specific surface area of the HAp/Col powder. On the other hand, adsorption of GNT molecules, less than 1 µm in size [
11], on the surface of the HAp/Col powder and/or filling of some pores would be the reason for this decrease. Thus, the size effect was ignored by the effect of GNT adsorption.
The relationship between adsorbed GNT at 24 h was approximated by Langmuir’s isotherm at R2 = 0.951 instead of Freundlich (R2 = 0.868), Temkin (R2 = 0.900), Dubinin–Radushkevich (R2 = 0.859), and BET (R2 = 0.694); accordingly, the GNT adsorption on the HAp/Col powder was considered to be Langmuir-type monomolecular layer adsorption.
HAp, one of the absorbent materials, has great potential for adsorption of positively charged GNT via the PO
4 site. On the other hand, GNT adsorption on the free amino and/or carboxyl groups in Col was reported [
12]. The HAp/Col formation is explained as follows: heterogenous nucleation of HAp nanocrystals preferentially occurs on carboxyl groups of Col, and Col fibers are covered with regularly aligned HAp nanocrystals to the fibers [
13]. Therefore, adsorption sites of the positively charged GNT on the HAp/Col powder would be limited by its nanostructure, negatively charged
c-plane on the HAp, and carboxyl group on the Col that are not covered by one-another. On the other hand, Guo, Y. J et al. [
10] reported that HAp particles with a specific surface area of 8.1 m
2/g adsorbed almost the same amount of GNT as the present HAp/Col powder. A five times greater specific surface area of HAp/Col showed no increase in GNT adsorption, as coverage of adsorption sites by HAp and Col in the HAp/Col compensated for the increasing effect of the specific surface area.
For desorption of GNT from GNT-HAp/Col powder, burst release is not suited to long-term drug release for curing diseases; however, for anti-infection activity, desorption of GNT has been considered as sufficient for preventing infection according to a report showcasing that 1 g of SEPTOPAL
® chain releases 2–3 mg of GNT in the same period [
14].
The results of antibacterial efficacy for high concentrations of E. coli by the shaking culture method suggest that GNT-HAp/Col powder has good potential for prevention of infection.
In comparison to the inhibition zone ratio of Ag-containing HAp compact (Ag-HAp) reported by Honda et al. [
15], the inhibition zone ratio of the GNT-HAp/Col powder compact at 48 h was larger than that of Ag-HAp. The inhibition zone test also suggested that the antibacterial efficacy of the GNT-HAp/Col would be sufficient up to 48 h. Ideally, an antibiotic-loaded bone cement should release antibiotics over a short period, after which the release should stop, in order to prevent subinhibitory concentrations thereafter, so as not to induce bacterial resistance [
16]. For the antibiotic-impregnated bone cement, Palacos
® bone cement also released gentamicin over a short period in the in vitro study and showed good antibiotic activities. From this effective theory, an anti-bacterial non-biodegradable implant, the AG-PROTEX
®, also focused on initial antibacterial properties. However, bacteria from inside of our bodies may also form a biofilm on the surface of implants. Furthermore, HAp/Col was expected to be less effective as a scaffold for forming biofilms because resorption of HAp/Col by osteoclasts starts at 5 days after implantation. Thus, antibiotic efficacy of the GNT-HAp/Col is considered as being sufficient for the prevention of IAI.
GNT was added as an antibiotic to cell culture medium at the recommended concentration of 0.05 mg/mL instead of the generally used penicillin and streptomycin. Concentration of GNT in the present cell culture medium supplemented with the GNTEL was at most 0.038 mg/mL, which is lower than the recommended concentration to avoid obvious harm to cells.
4. Materials and Methods
4.1. Preparation of HAp/Col and HAp/Col Powder
HAp/Col with a HAp/Col mass ratio of 4:1 was synthesized by the simultaneous titration method [
7]. Briefly, Ca(OH)
2, which was prepared by hydration of CaO obtained from heat decomposition of CaCO
3 (alkaline analysis grade, Wako Pure Chemicals Inc., Osaka, Japan), and orthophosphoric acid (reagent grade, Wako Pure Chemicals Inc., Osaka, Japan) aqueous solution containing porcine dermal type-I atelocollagen (biomaterial grade, Nitta Gelatin Inc., Yao, Japan) were simultaneously titrated into a reaction vessel, in which water was previously added, via tube pumps, maintaining the pH and temperature of the solution in the reaction vessel at 9 and for 37 °C, respectively. The amounts and concentrations of the starting materials were decided by calculation that the resulting HAp/Col became the target ratio under the ideal reaction [
7].
The obtained HAp/Col was compacted to a disk at 32 mm in diameter and 2 mm in thickness by a uniaxial pressing at 20 MPa for 18 h to squeeze water out of the obtained HAp/Col [
17]. The HAp/Col disk was frozen and freeze-dried at −20 °C, crushed by hand, and sorted into 100–212 μm by sieving. The HAp/Col powder was dehydrothermally cross-linked at 140 °C for 12 h in vacuo. Then, it was stirred in 20 mM CaCl
2 aqueous solution for 3 days to be saturated for Ca
2+ adsorption [
18], followed by filtering, freeze-drying, and re-sieving to collect the HAp/Col powder 100–212 μm in size. Morphologies of the prepared powder were observed with SEM (JSM-5600, JEOL, Akishima, Japan) at 20 kV acceleration voltage and 20 mA current. The specific surface area of the powder was calculated by the BET method from nitrogen adsorption data obtained with Belsorp II (MicrotracBEL Corp., Osaka, Japan).
4.2. Adsorption of GNT on HAp/Col Powder
Gentamicin sulfate (Wako Pure Chemical Co., Osaka, Japan) was chosen as a model antibiotic because it has many advantages such as low cost, effectiveness against most Gram-negative microorganisms, and low risk of generating resistant bacteria, and it is currently used for treatment of IAI by introduction into Palacos. The GNT stock solution was prepared by dissolution of 10 mg of the GNT powder with 10 mL of PBS (Gibco by Life Technologies, Thermo Fisher Scientific KK., Tokyo, Japan). Experimental GNT solutions at a concentration of 50, 100, or 250 μg/mL were prepared by serial dilution of the GNT stock solution with PBS. A total of 10 mg of the HAp/Col powder and 1 mL of the experimental GNT solution were added into a 1.5 mL centrifuge tube and mixed at 4 °C for 24 h with a rotating tube shaker at a rotation rate of 60 rpm. After mixing for 1, 5, 10, 15, 30, 60, 120, 180, 360, 720, or 1440 min, supernatant (500 µL) was collected after centrifugation at 12,000 rpm at 4 °C for 1 min, followed by storage at 4 °C until the quantitative analysis of the GNT (described in
Section 4.4). The experiment was performed in triplicate.
4.3. Desorption of GNT from GNT-HAp/Col Powder
Gentamicin sulfate-loaded HAp/Col powder was prepared for GNT desorption property measurement. A total of 300 mg of HAp/Col powder and 30 mL of 10 mg/mL GNT solution were mixed at room temperature for 24 h, and the powder phase was collected by centrifugation at 1200 rpm at 25 °C for 5 min, followed by aspiration of supernatant and freeze-drying of remaining powder at −20 °C for 48 h. After GNT-loading, mean powder size of GNT-HAp/Col powder was measured by the line-intercept method.
A total of 100 mg of GNT-HAp/Col powder was added into 10 mL of PBS in a 15 mL centrifuging tube, and was then placed in an incubator at 37 °C without any agitation. Then, 1 mL of supernatant was collected at days 1, 3, 5, 7, and 9. After each collection, 1 mL of fresh PBS was added to compensate for the decrease in liquid amount. Collected samples were stored at 4 °C until quantitative analysis of GNT (described in
Section 4.4). The experiment was performed in triplicate.
4.4. Quantification of GNT
The amount of GNT in solutions was measured by the Zhang [
19] modified Sampath’s [
20] method using o-phthaldialdehyde (OPA; Nakarai Tesque, Inc., Kyoto, Japan) solution. Briefly, 0.5 mL of OPA was thoroughly mixed with 0.5 mL of sample and 0.5 mL of 2-propanol (Nakarai Tesque, Inc., Kyoto, Japan), and was incubated at room temperature for 30 min. After incubation, absorbance of the mixture’s wavelength at 332 nm was measured with a UV-VIS spectrometer (V-650, JASCO Co., Tokyo, Japan).
4.5. Antibacterial Efficacy Test
A shaking culture method and inhibition zone assay were performed to evaluate the antibacterial efficacy of the extract and the in situ-leached GNT from the GNT-HAp/Col powder, respectively. E. coli, a common bacteria that causes infections, was used as the test bacterium. Suspension of E. coli was prepared using LB medium (Nihon Purechemical Co., Ltd., Tokyo, Japan) to recommend concentrations by JIS Z2801 (antibacterial products—test for antibacterial activity and efficacy) for each test condition.
4.5.1. Preparation of Samples for Antibacterial Efficacy Test
Extraction liquid of GNT and compacted GNT-HAp/Col powder were prepared for each test method using GNT-HAp/Col powder, which was prepared as described in
Section 4.3. Next, 15 mL centrifuge tubes containing 100 mg of GNT-HAp/Col powder and 10 mL of PBS were placed in an incubator at 37 °C without any agitation. After 1 or 5 day incubation, 8 mL of supernatant, GNT extraction liquid (respectively GNTEL 1 and GNTEL 5), was collected and sterilized by filtration. A compact disk of 12 mm in diameter and 1 mm in thickness was prepared by a uniaxial pressing of 100 mg of the GNT-HAp/Col powder at 50 MPa for 5 min, and was sterilized by ethylene oxide gas.
4.5.2. Shaking Culture Method
The lowest, 1 × 105 CFU/mL, and highest, 1 × 107 CFU/mL, E. coli concentrations described in the JIS were chosen for the test. A test mixture containing 1 × 105 (L) or 1 × 107 CFU/mL (H) E. coli was prepared in a 50 mL centrifuge tube by mixing of 1 mL of GNTEL 1 or 5, and 9 mL of LB medium containing appropriate concentrations of E. coli. The mixture was then incubated in a rotary shaker at 180 rpm in the dark at 37 °C for 18 h. After 18 h incubation, the concentration of E. coli was quantified with a UV/VIS spectrophotometer (GeneQuant 100, Biochrom. Ltd., Cambridge, UK). Mixed solutions that were prepared with 1 mL of PBS instead of GNTEL were used as controls.
4.5.3. Inhibition Zone Assay
Escherichia coli at 1 × 10
7 CFU were uniformly distributed on the surface of the LB agar plate. The compact was then placed on the center of the LB agar plate, and 500 μL LB medium was added from the top of the compact, followed by incubated at 37 °C in the dark. After 24 or 48 h of incubation, areas of the inhibition zones forming around the compact were measured with ImageJ (Ver. 1.52a for Windows 10, National Institute of Health, Bethesda, MD, USA) from three different JPEG images of 3024 × 3024 pixels taken with an iPhone SE (MLM62J/A, Apple Inc., USA). A compact of HAp/Col powder was used as a control. Inhibition zone ratios as given by the following formula were used:
where
Z1 and
Z2 are the area of the inhibition zone and powder compacts, respectively [
15].
4.6. Cytotoxicity Test
Cytotoxicity of the GNT-HAp/Col powder was evaluated by addition of GNTEL to culture medium using the MG-63 osteoblastic cell line derived from human osteosarcoma. Culture medium was Dulbecco’s modified Eagle’s medium (DMEM, Sigma-Aldrich, Inc., St. Louis, MO, USA) supplemented with 10% fetal bovine serum (FBS; Sigma-Aldrich, Inc., St. Louis, State of Missouri, USA) and 10% GNTEL collected on days 1, 3, (GNTEL 3) or 5. To clarify the effects of GNT leached from the GNT-HAp/Col, no antibiotics were added into the culture medium. Cell culture medium prepared with 10% PBS instead of GNTEL was used as a control.
One milliliter of MG-63 cell suspension at 1 × 104 cells/mL was prepared with each medium and was seeded into each well of a 12-well tissue culture plate (12-well Clear Flat Bottom TC-treated Multiwell Cell Culture Plate, FALCON, Becton Dickinson Co., Franklin Lakes, NJ, USA). Medium was changed every 2 days, and the number of cells was counted with a hemocytometer on days 1, 3, 5, and 7.